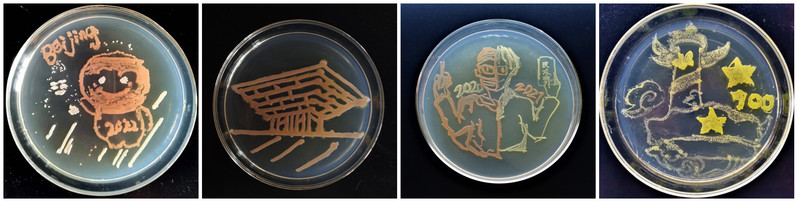

作者:张晓彦、徐亚飞 摄影:36365线路检测登录入口
在喜迎中国共产党成立100周年之际,参加第14届微生物竞赛决赛的同学们以培养皿为画布,以接种环为画笔,以不同微生物为颜料,创作出一幅幅描述党史故事的美丽画卷,生动展示了中国共产党成立100年来波澜壮阔的光辉历程,抒发了华理学子庆祝中国共产党成立100周年的喜悦之情,表达了青年大学生对党的忠诚热爱以及永远跟党走的坚定决心。

红船起航 新中国成立 香港澳门回归 建党百年
北京奥运 上海世博 民法典颁布 盛世中华

钟南山院士 白衣天使 袁隆平院士 抗疫志愿者

DNA双螺旋 校徽 分子结构式 疫苗接种
本次微生物竞赛从3月26日开始,历经初赛、复赛和决赛三个阶段。为了迎接中国共产党成立100周年,微生物竞赛组委会的评委老师们从60组上百幅初创草图中筛选出具有家国情怀、构思新颖的15个小组参加了决赛。在决赛阶段,组委会的老师和研究生们在学院实验中心的支持下,对微生物操作零基础的同学们进行手把手的细致指导,最终使构想的草图顺利展现在平板上。一个个小小的平板承载了老师和同学们拳拳的爱党、爱国、爱校的动人情怀。
谈到制作初心,生药203班史玉潇同学说:“恰逢建党百年之际,我们希望通过作品创作致敬中国共产党,表达对学校悉心培养的感激。这些作品融入了党史故事、生工专业特色DNA和校徽三要素组合,展现了生工青年学生永远跟党走的青春形象,同时激励我们不忘初心、不辱使命,为建设科技中国奉献力量!”生工2006班的雷陈雷谈到:“在持续抗击疫情的日子中迎来了中国共产党成立100周年,我们展现了医护人员和抗疫志愿者的形象,致敬这些最可爱的人,庆贺建党百年。这次实践活动也让我们意识到,要以求真务实的态度对待科学研究,要保持对科学研究的探索精神。”
本次活动是36365线路检测登录入口专业课程思政教育新思路的一次探索,通过“党建+专业”教育实践,创新思想政治教育工作模式。活动中结合专业课程学习,以微生物平板作画等学生喜闻乐见的形式开展主题学习教育活动,加强党史学习教育,强化思想引领和价值引领。学院通过课程思政与思政课程相结合,思想引领和专业教育相结合,理论学习与专业实践相结合,扎实推动大学生思政教育,喜庆建党百年。